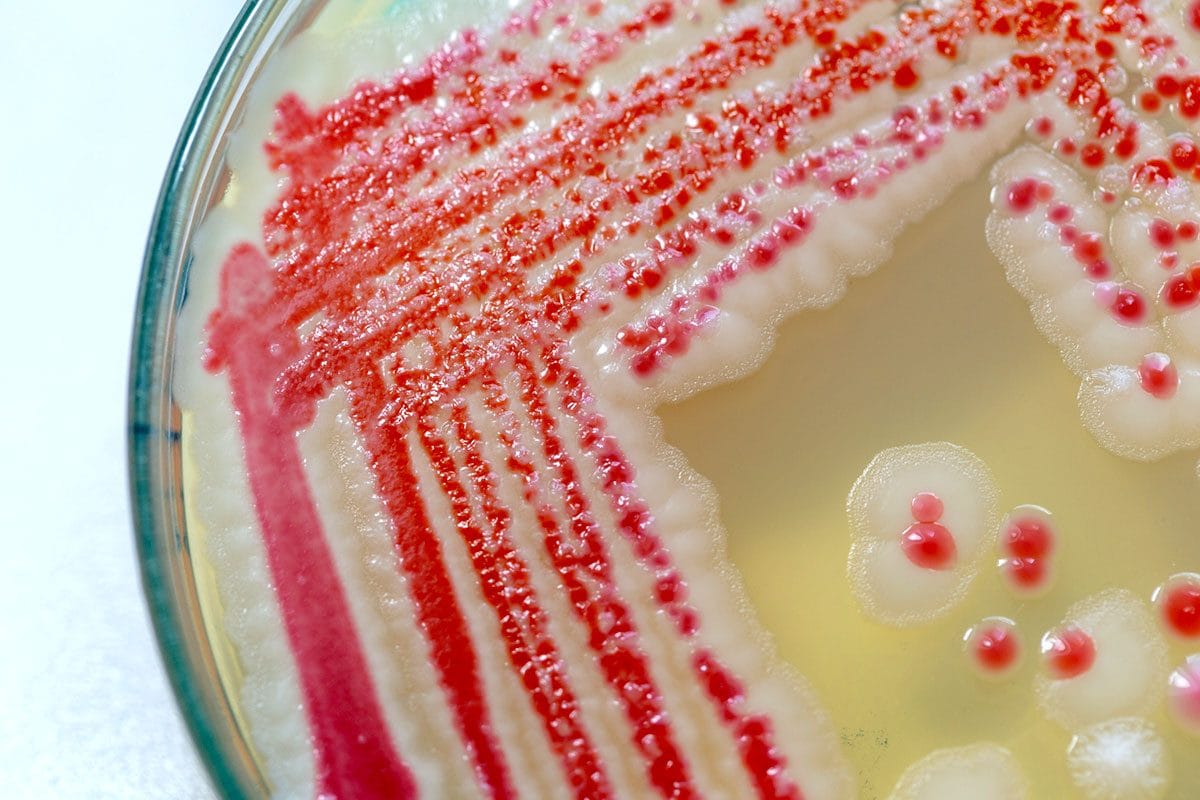
Neonati morti a Bolzano per infezione da batterio Serratia, cos’è e perché colpisce i più piccoli

Spagna, da una cucciolata nati due cani labrador dal pelo verde
pubblicato il 12 giugno 2014 alle ore 13:12
Valladolid, Castille and Leon, Spagna. Allevatori di cani sono rimasti scioccati dalla colorazione verde di due cuccioli di labrador appena nati, la cui causa è ancora oggetto di indagine. Solo due cuccioli della cucciolata nata il 3 giugno hanno presentato questa anomalia e uno dei due è morto poco dopo la nascita. Esistono precedenti casi di cani nati con il pelo verde, ma questa particolarità tende a svanire rapidamente dopo la nascita. Una simile anomalia può essere causata dell'esposizione alla biliverdina chimica in placenta, un pigmento presente nella bile.Fonte: RuptlyTV
mostra altro
altro di NotizieCuriose
-
2:15 La neve lo aveva bloccato in casa, ecco la magnifica reazione del veterano disabile
1272 VISUALIZZAZIONINotizieCuriose -
14 foto Come su un'isola deserta, raccolgono un ammasso di rami per costruirsi una capanna
8352 VISUALIZZAZIONINotizieCuriose -
0:52 Strani rumori dall'interno del furgone, stacca via una lamina e fa una scoperta sconvolgente
5660 VISUALIZZAZIONINotizieCuriose -
0:51 Bonsai fluttuante: non è un'allucinazione, ecco come avviene
7455 VISUALIZZAZIONINotizieCuriose -
0:16 Napoli, Unioni Civili: il video "Chi non salta, Pirellone è!" diventa virale
645 VISUALIZZAZIONINotizieCuriose -
10 foto Le 10 paure degli uomini quando fanno sesso con una donna per la prima volta
2335589 VISUALIZZAZIONINotizieCuriose -
4 foto Un vibratore a forma di foglia di marijuana, assicura momenti di vero godimento
4006 VISUALIZZAZIONINotizieCuriose -
11 foto Il bar dove cameriere sexy e camerieri muscolosi preparano il caffè
25668 VISUALIZZAZIONINotizieCuriose -
4 foto Ritrovano la loro cagnolina dopo 9 anni, a 1700 km da casa
4249 VISUALIZZAZIONINotizieCuriose -
0:53 Jennifer Lopez in forma smagliante, 46 anni e uno show da paura per i fan di Las Vegas
58694 VISUALIZZAZIONINotizieCuriose -
3:32 Come si faceva palestra negli anni '20? 100 anni di esercizi in 3 minuti
464 VISUALIZZAZIONINotizieCuriose -
1:20 "Impara a leggere i cartelli", Miss Colombia si "vendica" col presentatore di Miss Universo
287 VISUALIZZAZIONINotizieCuriose -
4 foto Gemelle identiche sposano due fratelli e partoriscono lo stesso giorno
37463 VISUALIZZAZIONINotizieCuriose -
4 foto Suo figlio non si fa più coccolare, la reazione di questa mamma vi farà sorridere
2630 VISUALIZZAZIONINotizieCuriose -
50 foto Questa è la scena originale, incredibile quello che diventa al cinema
16335 VISUALIZZAZIONINotizieCuriose -
2 foto Sull'aereo: si volta ed alle sue spalle c'è un tacchino, il motivo fa discutere
2485 VISUALIZZAZIONINotizieCuriose